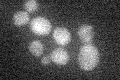
YIL135C
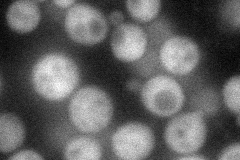
YIL135C
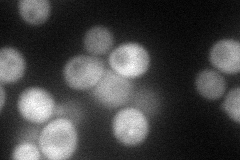
YIL135C
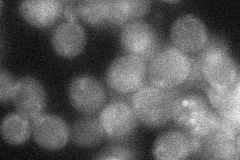
YIL135C
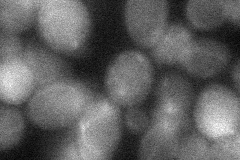
YIL135C
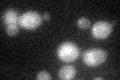
YIL135C

View description
Cytoplasmic protein of unknown function; identified as a high-copy suppressor of the synthetic lethality of a sis2 sit4 double mutant, suggesting a role in G1/S phase progression; similar to Mlf3p
Localization:
Intensity:
Fold change:
Significance:
-
C’ GFP library in SD
below threshold16.92 -
N' NOP1pr-GFP in SD
cytosol58.993 -
N' TEF2pr-mCherry in SD
cytosol55.797 -
N' NATIVEpr-GFP in SD
below threshold25.6152 -
N' TEF2pr-VC and Cyto-VN in SD
cytosol30.338 -
C’ GFP library in SD+DTT
cytosol16.390.96No -
C’ GFP library in SD+H2O2

cytosol16.961No -
C’ GFP library in Starvation Media

cytosol13.790.81No -
C’ GFP library on the background of Pup2-DaMP

below threshold -
C’ GFP library on the background of CCT mutant

below threshold17.28251.02128No
